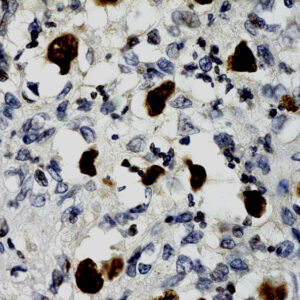
EBER Probe
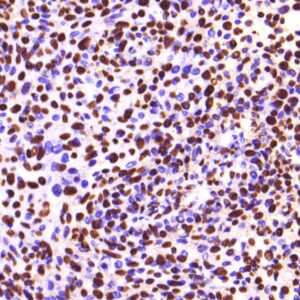
HPV 14 Probe

ISH Probes
BioGenex offers fluorescein-labeled oligonucleotide probes to detect DNA or RNA using In situ Hybridization (ISH). These probes allow quantitative detection of specific DNA/RNA sequences in their native form within the cells of formalin-fixed paraffin-embedded (FFPE) tissue sections. These probes offer reliable, highly sensitive, and easy-to-perform DNA and RNA ISH assays when used with the BioGenex ISH Detection Systems.
.